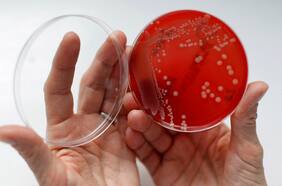

Zambia
10 NOVIEMBRE
10 NOVIEMBRE
04 NOVIEMBRE
03 ABRIL
26 DICIEMBRE
14 DICIEMBRE
22 SEPTIEMBRE
10 JULIO
21 JULIO
03 DICIEMBRE
Ocho casos positivos suspendieron el amistoso del martes frente a Chile. Por normativa del Minsal, la delegación del país africano deberá permanecer en el país, en una residencia sanitaria. La ANFP gestiona los pasajes de retorno.
Encerradas 14 días y con menú especial: la pesadilla de la delegación de Zambia contagiada por el COVID
01 DICIEMBRE
Lo más leído
1.
2.
3.
5.
Plan digital + LT Beneficios por 3 meses
Comienza el año bien informado y con beneficios para ti ⭐️$3.990/mes SUSCRÍBETE